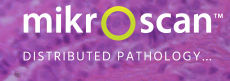
Mikroscan Technologies, Inc.

预约演示
更新于:2026-02-02
Mikroscan Technologies, Inc.
更新于:2026-02-02
概览
关联
100 项与 Mikroscan Technologies, Inc. 相关的临床结果
登录后查看更多信息
0 项与 Mikroscan Technologies, Inc. 相关的专利(医药)
登录后查看更多信息
3
项与 Mikroscan Technologies, Inc. 相关的新闻(医药)2023-08-07
CHICAGO, Aug. 7, 2023 /PRNewswire/ -- In the near future, the blood culture tests industry is poised for remarkable advancements driven by cutting-edge technologies and innovative research. With a growing emphasis on personalized medicine and rapid diagnostic solutions, blood culture tests will witness a transformative shift towards faster, more accurate, and comprehensive detection of infectious agents. Microfluidic-based platforms will become increasingly prevalent, enabling higher-throughput analysis and reduced turnaround times, crucial for early detection and effective treatment of infections. Additionally, advancements in machine learning algorithms and artificial intelligence will facilitate the real-time analysis of vast datasets, improving pathogen identification and antibiotic resistance profiling. Furthermore, the integration of point-of-care blood culture devices with telemedicine and cloud-based platforms will enhance accessibility and facilitate seamless communication between healthcare providers and patients. As the industry continues to thrive, these advancements will play a pivotal role in revolutionizing infectious disease diagnosis and treatment, ultimately leading to improved patient outcomes and global healthcare systems.
Blood Culture Tests Market in terms of revenue was estimated to be worth $5.2 billion in 2023 and is poised to reach $7.6 billion by 2028, growing at a CAGR of 8.0% from 2023 to 2028 according to a new report by MarketsandMarkets™.
Growth in this market is primarily fueled by growing demand for rapid diagnostic techniques, high prevalence of infectious diseases, growing incidence of sepsis cases and high-cost treatment, rising geriatric population and high incidence of bloodstream infections. Alternatively, lack of trained laboratory technicians and high cost of automated instruments are expected to restrain the market growth in the upcoming years.
Download an Illustrative overview:
Browse in-depth TOC on "Blood Culture Tests Market"
269 - Tables
43 - Figures
276 - Pages
Blood Culture Tests Market
Scope:
The Automated Blood Culture Tests segment is expected to grow the highest during the forecast period
Based on method, conventional/manual blood culture and automated blood culture methods are the different blood culture tests market segments. The automated blood culture segment is expected to grow the highest during the forecast period. The quick turnaround time and reduced risk of contamination due to low manual intervention drives the growth of the automated blood culture method segment in the blood culture tests market.
The Consumables segment is expected to grow the highest during the forecast period
Based on product, the consumables, instruments, and software and services, make up the major market segments for blood culture tests market. The consumables segment not only has the largest share but is also expected to grow the highest during the forecast period. The large share of this segment is attributed to the repeated purchase of media for the detection of bacteria, fungi, and yeast and increase in drug-resistant infections, such as methicillin-resistant Staphylococcus aureus (MRSA) and extended-spectrum beta-lactamase (ESBL)-producing bacteria.
The Molecular Technologies segment is to witness the highest growth during the forecast period
Based on technology, the blood culture tests market is categorized into distinct segments, including molecular technologies, proteomics and culture-based technologies. Among these, molecular technologies segment is to witness the highest growth during the forecast period. This can be attributed to several factors, such as the increasing incidence of sepsis, which demands rapid diagnostic techniques for detecting the presence of fungi, bacteria, and mycobacteria from blood samples.
The Bacteremia segment is expected to look for the highest growth during the forecast period
Based on application, the market for blood culture tests is divided into fungemia, mycobacterial detection and bacteremia. Bacteremia segment is expected to look for the highest growth in the blood culture tests market. The highest growth of this segment is primarily attributed to the increasing number of bloodstream infections and the growing number of sepsis cases worldwide.
The Hospital Laboratories segment has accounted for the largest share during the forecast period
Based on end users, the bloodculture tests market is bifurcated into reference laboratories,hospital laboratories, academic research laboratories, and other laboratories (includes physician office laboratories (POLS), pathology laboratories, independent research laboratories and bacteriological laboratories). The hospital laboratories segment has accounted for the largest share in this market. This is due to the rising number of sepsis cases in emergency departments (EDs), as sepsis is most commonly observed in EDs.
Asia-Pacific is to witness the highest growth during the forecast period.
The Asia-pacific blood culture tests market is expected to grow at the highest CAGR during the forecast period of 2023-2028. The high growth rate of this market can be attributed to the high prevalence of sepsis and government initiatives to increase its awareness, increasing demand for effective diagnostic techniques, and growing regulatory approvals and availability of blood culture test products in the region.
Request Sample Pages:
Blood Culture Tests Market
Dynamics:
Drivers:
Growing incidence of sepsis cases and high cost of treatment
Restraints:
Lack of trained laboratory technicians
Opportunities:
Growth opportunities in emerging economies
Challenges:
Market Cannibalization for conventional products
Key Market Players:
The major players in this market are Biosystems, Inc (US), BINDER GmBH (Germany), Biobase Biotech (Jinan) Co., Ltd. (China), Scenker Biological Technology Co., Ltd. (China), Bulldog Bio (England), Anaerobe Systems, Inc. (US), Himedia Laboratories Pvt. Ltd. (India), Autobio Diagnostics Co., Ltd. (China), Axiom Laboratories (India), Mikroscan Technologies, Inc. (US), Labotronics Ltd. (UK), Hardy Diagnostics (US), OpGen, Inc. (US), Meditech Technologies India Private Limited (India), Iridica (US), Thermo Fisher Scientific (US), Danaher (US), Luminex Corporation (US), Bruker (US), Roche Diagnostics (Switzerland), Carl Zeiss AG (Germany), Nikon Corporation (Japan), Terumo Corporation (Japan), Becton, Dickinson and Company (US) and BioMérieux (France).
Recent Developments:
In 2023, BioMérieux, announced that it has submitted a 510(k) premarket notification to the US Food and Drug Administration (FDA) for the VITEK REVEAL, formerly known as SPECIFIC REVEALRapid AST System. This rapid, modular, antimicrobial-susceptibility test platform that can deliver actionable results for Gram-negative bacteria directly from positive blood cultures in an average of five and a half hours1 enabling same-day treatment decision-making for patients suffering from bacteremia sepsis.
In 2023, Bruker introduces fast next-generation MALDI Biotyper IVD Software. The MBT Compass HT IVD software provides a high sample throughput for microbial identification with time-to-result of ~5 minutes for 96 sample spots. Because of a fast sample target exchange, the MBT system can now analyze up to 600 samples per hour, while covering over 4,600 species in the reference library.
In 2022, BioMérieux, a world leader in the field of in vitro diagnostics, has entered into an agreement to acquire Specific Diagnostics, a privately held US based company that has developed a rapid antimicrobial susceptibility test (AST) system that delivers phenotypic AST directly from positive blood cultures. BioMérieux has held a minority stake in Specific Diagnostics since 2019, and the two companies had signed a co-distribution agreement covering the European market in 2021. With the addition of SPECIFIC REVEAL Rapid AST, the unique and comprehensive BioMérieux Sepsis Solution allows same-day AST results for Gram-negative bacteria to enable more targeted therapy and improve patient outcomes.
In 2022, Beckman Coulter, partnered with Germany-based company Smart4Diagnostics to close the preanalytical data gap between blood collection and laboratory analysis due to errors that take place before the sample arrives in the laboratory, such as sample collection, patient identification, sample handling, sample transportation, sample loss, etc.
In 2020, Becton, Dickinson and Company obtained the CE mark approval for the BD Vacutainer UltraTouch Push Button Blood Collection Set (BCS) with Preattached Holder. The one-handed safety activation of the push button allows clinicians to activate the safety mechanism while still attending to the patient and venipuncture site.
Get 10% Free Customization on this Report:
Blood Culture Tests Market Advantages:
Early Detection of Infections: Blood culture tests are highly sensitive and can detect a wide range of bacterial, fungal, and viral infections in the bloodstream, even before symptoms become apparent. Early detection allows for prompt initiation of appropriate treatment, improving patient outcomes and reducing the risk of complications.
Guiding Targeted Antibiotic Therapy: Identifying the specific pathogen causing the infection enables healthcare providers to prescribe targeted antibiotic therapy. This approach minimizes the unnecessary use of broad-spectrum antibiotics, reducing the risk of antibiotic resistance and preserving the effectiveness of antibiotics for future use.
Monitoring Treatment Effectiveness: Blood culture tests enable healthcare professionals to monitor the effectiveness of antibiotic treatment over time. Serial blood cultures can show a decline in pathogen levels, indicating successful therapy, or the emergence of antibiotic resistance, prompting adjustments to the treatment plan.
Infection Control in Healthcare Settings: Blood culture tests play a vital role in identifying outbreaks of infectious diseases in healthcare facilities. Timely detection and appropriate infection control measures help prevent the spread of infections among patients and healthcare workers.
Impact on Public Health: Blood culture tests contribute valuable data to public health surveillance systems, aiding in the identification and tracking of emerging infectious diseases. This information assists health authorities in implementing targeted interventions and preventive measures at a broader level.
Personalized Medicine: With advancements in technology, blood culture tests are becoming more accessible and adaptable to individual patient needs. This fosters the concept of personalized medicine, tailoring treatment plans based on the specific pathogens and their drug resistance profiles found in a patient's bloodstream.
Non-Invasive Alternatives: In some cases, blood culture tests can replace more invasive diagnostic procedures, such as tissue biopsies or lumbar punctures, reducing patient discomfort and potential complications.
Research and Development: Blood culture test data fuels ongoing research and development efforts, leading to the creation of improved diagnostic tools, new antimicrobial agents, and enhanced treatment strategies.
In conclusion, the blood culture tests market's advantages lie in its ability to offer early and accurate detection of infections, guide targeted therapies, contribute to infection control and public health efforts, foster personalized medicine, and support medical research and development. These benefits collectively contribute to better patient care, improved public health outcomes, and the advancement of medical knowledge in the field of infectious diseases.
Related Reports:
Blood Collection Devices Market - Global Forecasts to 2027
Sepsis Diagnostics Market - Global Forecasts to 2026
Blood Screening Market - Global Forecasts to 2026
Clinical Microbiology Market - Global Forecasts to 2025
Patient Blood Management Market - Global Forecasts to 2024
About MarketsandMarkets™:
MarketsandMarkets™ is a blue ocean alternative in growth consulting and program management, leveraging a man-machine offering to drive supernormal growth for progressive organizations in the B2B space. We have the widest lens on emerging technologies, making us proficient in co-creating supernormal growth for clients.
The B2B economy is witnessing the emergence of $25 trillion of new revenue streams that are substituting existing revenue streams in this decade alone. We work with clients on growth programs, helping them monetize this $25 trillion opportunity through our service lines - TAM Expansion, Go-to-Market (GTM) Strategy to Execution, Market Share Gain, Account Enablement, and Thought Leadership Marketing.
Built on the 'GIVE Growth' principle, we work with several Forbes Global 2000 B2B companies - helping them stay relevant in a disruptive ecosystem. Our insights and strategies are molded by our industry experts, cutting-edge AI-powered Market Intelligence Cloud, and years of research. The KnowledgeStore™ (our Market Intelligence Cloud) integrates our research, facilitates an analysis of interconnections through a set of applications, helping clients look at the entire ecosystem and understand the revenue shifts happening in their industry.
To find out more, visit ™.com or follow us on Twitter, LinkedIn and Facebook.
Contact:
Mr. Aashish Mehra
MarketsandMarkets™ INC.
630 Dundee Road
Suite 430
Northbrook, IL 60062
USA: +1-888-600-6441
Email: [email protected]
Research Insight:
Visit Our Website:
Content Source:
Logo:
SOURCE MarketsandMarkets
2023-06-15
CHICAGO, June 15, 2023 /PRNewswire/ -- The digital pathology industry is poised for remarkable growth and transformation in the near future. With advancements in technology and the increasing demand for efficient and accurate diagnostic solutions, digital pathology is set to revolutionize healthcare systems worldwide. The integration of artificial intelligence and machine learning algorithms with digital pathology platforms will enable pathologists to analyze and interpret large volumes of digital slides more efficiently, leading to faster and more accurate diagnoses. Moreover, the widespread adoption of telepathology will facilitate remote consultations and second opinions, bridging the gap between experts and underserved areas. This digital revolution in pathology will not only enhance patient care by enabling faster diagnosis and personalized treatment plans but also streamline pathology workflows, reduce costs, and facilitate data-driven research for improved clinical outcomes.
Digital Pathology Market in terms of revenue was estimated to be worth $0.9 billion in 2023 and is poised to reach $1.8 billion by 2028, growing at a CAGR of 13.6% from 2023 to 2028 according to a new report by MarketsandMarkets™. The digital pathology market is mainly driven by factors such as the growing applications of digital pathology in drug development and companion diagnostics, growing awareness of early cancer diagnosis in emerging economies, and recommendations for cancer screening. On the other hand, the high costs of digital pathology systems are expected to restrain market growth to a certain extent.
Download an Illustrative overview:
Browse in-depth TOC on "Digital Pathology Market"
248 - Tables
48 - Figures
274 - Pages
Digital Pathology Market
Scope:
The human pathology segment has accounted for the largest market share during the forecast period.
Based on type, the digital pathology market is segmented into human pathology and veterinary pathology. The human pathology segment accounted for the largest share of 66.5% of digital pathology type market in 2022. The growing awareness of early cancer diagnosis in emerging economies, and increasing collaborations among academic research institutes, universities, and pathology laboratories drives the growth of the human pathology segment in the digital pathology market.
The scanners segment accounted for the largest share of 44.9% of the global digital pathology market
Basesd on product, the global digital pathology market is segmented into scanners, software, and storage systems. The scanners segment accounted for the largest share of 44.9% of the global digital pathology market in 2022. The large share of this segment can be attributed to the restrictions implemented in many countries owing to the COVID-19 outbreak are also expected to increase the installation of scanners to promote the remote viewing of tests by pathologists.
Drug discovery was the largest application segment of the digital pathology market.
Based on application, the digital pathology market is segmented into drug discovery, disease diagnosis, and training & education. In 2022, drug discovery was the largest application segment of the digital pathology market. The growth in the rising number of preclinical & clinical studies, high throughput screening and imaging, and increasing use of toxicology testing for illicit drugs are the major factors responsible for the large share of the drug discovery application segment.
North America accounted for the largest share of the Digital Pathology market
In 2022, North America accounted for the largest share and highest growth rate of the digital pathology market in 2022. The highest growth rate of the market can be attributed to the rising prevalence of cancer, growing geriatric population, and the presence of well-developed healthcare infrastructure in the region are expected to drive the growth of the market in North America.
Request Sample Pages:
Digital Pathology Market
Dynamics:
Drivers:
Increasing adoption of digital pathology to enhance lab efficiency
Rising incidence of cancer
Growing applications of digital pathology in drug development and companion diagnostics
Growing awareness of early cancer diagnosis in emerging economies
Recommendations for cancer screening
Restraints:
High cost of digital pathology systems
Opportunities:
Introduction of affordable scanners for private pathology practices
Growing demand for personalized medicine
High growth opportunities in emerging economies
Challenges:
Shortage of trained pathologists
Key Market Players:
The Digital Pathology Market is highly consolidated. Some of the major players operating in this market include Danaher Corporation (US), Koninklijke Philips N.V. (Netherlands), KONFOONG BIOTECH INTERNATIONAL CO., F. Hoffmann-La Roche Ltd. (Switzerland), XIFIN, Inc. (US), Apollo Enterprise Imaging (US), Huron Digital Pathology (Canada), Hologic, Inc. (US), Kanteron Systems (Spain), Corista (US), Objective Pathology Services Limited (Canada), Aiforia (Finland), Glencoe Software, Inc. (US), Motic Digital Pathology (US), OptraSCAN (US), Sectra AB (Sweden), Mikroscan Technologies, Inc. (US), Indica Labs Inc. (US), 3DHISTECH (Hungary), Akoya Biosciences, Inc. (US), Fujifilm Holdings Corporation (Japan), Paige AI, Inc. (US), Proscia Inc. (US), LTD. (China), PathAI (US), and Hamamatsu Photonics K.K. (Japan).
Get 10% Free Customization on this Report:
Recent Developments:
In 2022, Danaher Corporation partnered with Indica Labs to deliver compatible digital pathology workflow solutions by maintaining file compatibility between Leica Biosystems Aperio GT 450 family of scanners with Indica Labs Halo family of software solutions.
In 2022, Hamamatsu received US FDA 510(k) clearance for the NanoZoomer S360MD Slide scanner system for primary diagnostic use.
In 2022, F. Hoffmann-LA roche ltd. Launched the VENTANA DP 600 slide scanner for digital pathology, enhancing patient care with precision diagnostics.
In 2021, Koninklijke Philips launched the next-generation digital pathology solution, which features a comprehensive and scalable suite of software tools and capabilities in digital pathology.
Digital Pathology Market Advantages:
Improved Efficiency: Digital pathology eliminates the need for physical slides and enables the digitization of tissue samples. This streamlines the entire pathology workflow, reducing the time and effort required for slide preparation, transportation, and storage. Pathologists can access digital slides instantly, enabling faster diagnosis and treatment decisions.
Enhanced Collaboration: Digital pathology enables seamless collaboration among pathologists, regardless of their geographical locations. It allows for easy sharing of digital slides, facilitating second opinions, consultations, and multidisciplinary discussions. This collaborative approach can lead to more accurate diagnoses and improved patient outcomes.
Cost Savings: Digital pathology reduces costs associated with slide preparation, storage, and transportation. It eliminates the need for physical slide archiving, freeing up valuable laboratory space. Additionally, remote consultations and telepathology services minimize the need for physical travel, reducing expenses and increasing accessibility to expert opinions.
Data Management and Analysis: Digital pathology platforms offer robust data management capabilities, allowing pathologists to store, organize, and analyze large volumes of digital slides and associated clinical data. Advanced image analysis algorithms and machine learning techniques can assist pathologists in detecting patterns, identifying biomarkers, and predicting patient outcomes, contributing to personalized medicine and research advancements.
Education and Training: Digital pathology provides valuable educational opportunities for pathologists in training. They can access a vast repository of digital slides for learning purposes, participate in virtual case discussions, and gain exposure to a wider range of pathologies. This technology-driven approach enhances the learning experience and helps in standardizing diagnostic practices.
Overall, the digital pathology market offers numerous advantages, including improved efficiency, enhanced collaboration, cost savings, advanced data analysis capabilities, and educational opportunities. These advantages have the potential to revolutionize pathology practices and significantly improve patient care in the future.
Digital Pathology Market – Report Highlights:
UPDATED MARKET OVERVIEW:
The current edition of the report consists of an updated market overview, along with the updated market assessment across all segments from 2021 to 2028. Also, it includes value chain analysis, Porter's five forces analysis, average selling price trends of key players, regulatory analysis, key conferences, and events in 2022-2023, key stakeholders and buying criteria, and trade analysis have been provided in the market overview chapter.
UPDATED COMPETITIVE LANDSCAPE CHAPTER:
The competitive landscape chapter has been updated with the company evaluation quadrant and company evaluation quadrant for start-ups/SMEs. The competitive landscape also includes the revenue share analysis of the top players, market share analysis, competitive benchmarking, and company footprint of the global market.
UPDATED COMPANY PROFILES:
The new edition of the report includes profiles for Danaher Corporation (US), Hologic, Inc. (US), Akoya Biosciences, Inc. (US), and Fujifilm Holdings Corporation (Japan).
UPDATED FINANCIAL INFORMATION/PRODUCT PORTFOLIOS OF PLAYERS:
The new edition of the report provides updated financial information in the context of the digital pathology market until 2022 for each listed company in a graphical representation in a single diagram (instead of multiple tables). This will easily help analyze the present status of profiled companies in terms of their financial strength, key revenue-generating country/region, business segment focus in terms of the highest revenue-generating segment, and investments in R&D activities.
UPDATED MARKET DEVELOPMENTS OF PROFILED PLAYERS:
Recent developments are important to understand the market trend and growth strategies adopted by players in the global digital pathology market space. The current edition of this report provides updated developments of profiled players from January 2019 to February 2023, indicating a continuation of the previous version. Product launches, mergers, and acquisitions are the principal growth strategies adopted by market players in this period.
ADDITION OF RECESSION IMPACT:
The current edition of the report consists of the impact of the recession on the digital pathology market.
A section on the impact of the recession on all regional markets, such as North America, Asia Pacific, Europe, Latin America, and Middle East & Africa have been included.
Related Reports:
Dental Digital X-ray Market - Global Forecasts to 2027
X-Ray Detectors Market - Global Forecasts to 2027
Tissue Diagnostics Market - Global Forecasts to 2027
Digital X-Ray Market - Global Forecasts to 2026
Anatomic Pathology Market - Global Forecasts to 2026
About MarketsandMarkets™:
MarketsandMarkets™ is a blue ocean alternative in growth consulting and program management, leveraging a man-machine offering to drive supernormal growth for progressive organizations in the B2B space. We have the widest lens on emerging technologies, making us proficient in co-creating supernormal growth for clients.
The B2B economy is witnessing the emergence of $25 trillion of new revenue streams that are substituting existing revenue streams in this decade alone. We work with clients on growth programs, helping them monetize this $25 trillion opportunity through our service lines - TAM Expansion, Go-to-Market (GTM) Strategy to Execution, Market Share Gain, Account Enablement, and Thought Leadership Marketing.
Built on the 'GIVE Growth' principle, we work with several Forbes Global 2000 B2B companies - helping them stay relevant in a disruptive ecosystem. Our insights and strategies are molded by our industry experts, cutting-edge AI-powered Market Intelligence Cloud, and years of research. The KnowledgeStore™ (our Market Intelligence Cloud) integrates our research, facilitates an analysis of interconnections through a set of applications, helping clients look at the entire ecosystem and understand the revenue shifts happening in their industry.
To find out more, visit ™.com or follow us on Twitter, LinkedIn and Facebook.
Contact:
Mr. Aashish Mehra
MarketsandMarkets™ INC.
630 Dundee Road
Suite 430
Northbrook, IL 60062
USA: +1-888-600-6441
Email: [email protected]
Research Insight:
Visit Our Website:
Content Source:
Logo:
SOURCE MarketsandMarkets
2022-10-07
DUBLIN, Oct. 7, 2022 /PRNewswire/ -- The "Digital Pathology Market by Product( ArtificiaI Intelligence, Scanner, Software, Storage), Type(Human, Veterinary), Application( Teleconsultation, Training, Disease Diagnosis, Drug Discovery), End User( Pharma, Academia, Hospitals ) - Global Forecast to 2026" report has been added to
ResearchAndMarkets.com's offering.
The global digital pathology market is projected to reach USD 1,371 million by 2026 from USD 736 million in 2021, at a CAGR of 13.2% during the forecast period.
The growth in the digital pathology market is mainly driven by factors such as the increasing adoption of digital pathology to enhance lab efficiency, rising incidence of cancer, and growing applications of digital pathology in drug development and companion diagnostics. On the other hand, the high costs of digital pathology systems are expected to restrain market growth to a certain extent.
The scanners segment accounted for the largest share of the Digital Pathology market in 2020.
Based n products, the digital pathology market has been segmented into scanners, software, and storage systems. The large share of the scanners segment can be attributed to the high price of scanners and the increasing adoption of digital pathology solutions.
The human pathology segment accounted for the largest share of the Digital Pathology market in 2020
Based on type, the global digital pathology market is segmented into human pathology and veterinary pathology. The human pathology segment accounted for the largest share of the digital pathology market in 2020. This is due to the increasing number of cancer research activities and growing collaborations among research institutes, universities, and pathology laboratories.
The drug discovery, segment accounted for the largest share of the Digital Pathology market in 2020.
Based on application, the digital pathology market is segmented into drug discovery, disease diagnosis, and training & education. The drug discovery segment accounted for the largest share of the digital pathology market in 2020. Growth in R&D expenditure fueled by the need for numerous preclinical and clinical studies performed during the drug discovery and development process is a major factor responsible for market growth.
The pharmaceutical & biotechnology companies, segment accounted for the largest share of the Digital Pathology market in 2020.
Based on end users, the global digital pathology market is segmented into pharmaceutical & biotechnology companies, hospitals & reference laboratories, and academic & research institutes. The pharmaceutical & biotechnology companies segment accounted for the largest share of the digital pathology market in 2020. The large share of this segment can be attributed to the increasing use of digital pathology for drug discovery studies and drug toxicology testing. Biotechnology companies also use digital pathology for biobanking, biopharmaceutical studies, molecular assays, and the development of individualized medicine.
The market in North America is projected to witness the highest growth rate during the forecast period (2021-2026).
North America accounted for the largest share of the digital pathology market in 2020. The increasing prevalence of cancer, rising demand for quality diagnostics, the introduction of favorable reimbursement policies, and the implementation of favorable initiatives by the governments in the US and Canada are major factors driving the growth of the digital pathology market in North America.
Key Topics Covered:
1 Introduction
2 Research Methodology
3 Executive Summary
4 Premium Insights
4.1 Digital Pathology Market Overview
4.2 North America: Digital Pathology Market, by End-User & Country (2020)
4.3 Digital Pathology Market: Geographic Growth Opportunities
4.4 Regional Mix: Digital Pathology Market (2021-2026)
4.5 Digital Pathology Market: Developing Vs. Developed Markets
5 Market Overview
5.1 Introduction
5.2 Market Dynamics
5.2.1 Drivers
5.2.1.1 Increasing Adoption of Digital Pathology to Enhance Lab Efficiency
5.2.1.2 Rising Incidence of Cancer
5.2.1.3 Growing Applications of Digital Pathology in Drug Development and Companion Diagnostics
5.2.2 Restraints
5.2.2.1 High Cost of Digital Pathology Systems
5.2.3 Opportunities
5.2.3.1 Introduction of Affordable Scanners for Private Pathology Practices
5.2.3.2 Growing Demand for Personalized Medicine
5.2.3.3 High Growth Opportunities in Emerging Economies
5.2.4 Challenges
5.2.4.1 Shortage of Trained Pathologists
5.3 COVID-19 Impact Analysis
5.3.1 Impact of COVID-19 on the Digital Pathology Market
5.4 Ecosystem Market Map
5.5 Trends in Average Selling Price
5.6 Impact of the New Ivd Regulation on Different Markets
5.6.1 Impact on Clinical Lab Services
5.6.2 Impact on Ivd
5.6.3 Impact on Digital Pathology
5.7 Technology Analysis
5.7.1 Artificial Intelligence (Ai) in Digital Pathology
5.8 Patent Analysis
5.8.1 Methodology
5.8.2 Publication Trends
5.8.3 Jurisdiction Analysis
5.8.4 Top Applicants
6 Digital Pathology Market, by Product
6.1 Introduction
6.2 Scanners
6.2.1 Scanners Accounted for the Largest Share of the Digital Pathology Products Market in 2020
6.2.1.1 Brightfield Scanners
6.2.1.2 Other Scanners
6.3 Software
6.3.1 Integrated Software
6.3.1.1 Integrated Software Segment to Dominate the Market During the Forecast Period
6.3.2 Standalone Software
6.3.2.1 Information Management Software
6.3.2.1.1 Information Management Software Enables Comprehensive Integration with Any Institute's Information Systems
6.3.2.2 Image Analysis Software
6.3.2.2.1 Image Analysis Software Provides Easy-To-Use Solutions for the Quantitative Evaluation of Brightfield Slides
6.4 Storage Systems
6.4.1 Requirement for the Safe and Reliable Storage of High-Quality Images to Ensure Market Growth
7 Digital Pathology Market, by Type
7.1 Introduction
7.2 Human Pathology
7.2.1 the COVID-19 Pandemic Has Led to An Increasing Demand for Digital Pathology Solutions
7.3 Veterinary Pathology
7.3.1 Veterinary Digital Pathology Reduces the Turnaround Time for Animal Disease Diagnosis?Key Factor Driving the Market Growth
8 Digital Pathology Market, by Application
8.1 Introduction
8.2 Drug Discovery
8.2.1 Increasing R&D Spending to Drive the Growth of this Segment
8.3 Disease Diagnosis
8.3.1 Use of Artificial Intelligence and Machine Learning in Digital Pathology Solutions for Diagnostic Purposes to Drive Market Growth
8.4 Training & Education
8.4.1 Digital Pathology Can Improve Education & Training Provided to Pathologists in Academic Institutes
9 Digital Pathology Market, by End-User
9.1 Introduction
9.2 Pharmaceutical & Biotechnology Companies
9.2.1 Pharmaceutical & Biotechnology Companies Are the Largest & Fastest-Growing End-Users of the Digital Pathology Market
9.3 Hospitals & Reference Laboratories
9.3.1 Increasing Adoption of Digital Pathology Solutions in Hospitals to Drive the Growth of this Segment
9.4 Academic & Research Institutes
9.4.1 Funding Investments and Initiatives to Boost the Growth of this End-User Segment in the Digital Pathology Market
10 Digital Pathology Market, by Region
11 Competitive Landscape
11.1 Overview
11.2 Key Player Strategies/Right-To-Win
11.3 Revenue Share Analysis of Top Market Players
11.4 Competitive Benchmarking
11.5 Competitive Leadership Mapping
11.5.1 Stars
11.5.2 Emerging Leaders
11.5.3 Pervasive Players
11.5.4 Participants
11.6 Competitive Leadership Mapping for Other Companies
11.6.1 Progressive Companies
11.6.2 Dynamic Companies
11.6.3 Starting Blocks
11.6.4 Responsive Companies
11.7 Market Share Analysis
11.8 Competitive Scenario
11.8.1 Product Launches and Approvals
11.8.2 Deals
12 Company Profiles
12.1 Key Players
12.1.1 Leica Biosystems
12.1.1.1 Business Overview
12.1.1.2 Products & Services Offered
12.1.1.3 Recent Developments
12.1.1.4 Analyst's View
12.1.1.4.1 Right-To-Win
12.1.1.4.2 Strategic Choices Made
12.1.1.4.3 Weaknesses and Competitive Threats
12.1.2 Koninklijke Philips N.V.
12.1.2.1 Business Overview
12.1.2.2 Products & Services Offered
12.1.2.3 Recent Developments
12.1.2.4 Analyst's View
12.1.2.4.1 Right-To-Win
12.1.2.4.2 Strategic Choices Made
12.1.2.4.3 Weaknesses and Competitive Threats
12.1.3 Hamamatsu Photonics
12.1.3.1 Business Overview
12.1.3.2 Products & Services Offered
12.1.3.3 Recent Developments
12.1.3.4 Analyst's View
12.1.3.4.1 Right-To-Win
12.1.3.4.2 Strategic Choices Made
12.1.4 F. Hoffmann-La Roche Ltd.
12.1.4.1 Business Overview
12.1.4.2 Products Offered
12.1.4.3 Recent Developments
12.1.4.4 Analyst's View
12.1.4.4.1 Right-To-Win
12.1.4.4.2 Strategic Choices Made
12.1.5 Sectra Ab
12.1.5.1 Business Overview
12.1.5.2 Products Offered
12.1.5.3 Recent Developments
12.1.5.4 Analyst's View
12.1.5.4.1 Right-To-Win
12.1.5.4.2 Strategic Choices Made
12.1.6 Akoya Biosciences
12.1.6.1 Business Overview
12.1.6.2 Products Offered
12.1.6.3 Recent Developments
12.1.7 3Dhistech
12.1.7.1 Business Overview
12.1.7.2 Products Offered
12.1.7.3 Recent Developments
12.1.8 Apollo Enterprise Imaging Corp.
12.1.8.1 Business Overview
12.1.8.2 Products Offered
12.1.8.3 Recent Developments
12.1.9 Xifin, Inc.
12.1.9.1 Business Overview
12.1.9.2 Products Offered
12.1.9.3 Recent Developments
12.1.10 Huron Digital Pathology
12.1.10.1 Business Overview
12.1.10.2 Products Offered
12.1.10.3 Recent Developments
12.1.11 Visiopharm
12.1.11.1 Business Overview
12.1.11.2 Products Offered
12.1.11.3 Recent Developments
12.1.12 Corista
12.1.12.1 Business Overview
12.1.12.2 Products Offered
12.1.12.3 Recent Developments
12.1.13 Indica Labs
12.1.13.1 Business Overview
12.1.13.2 Products Offered
12.1.13.3 Recent Developments
12.1.14 Objective Pathology Services
12.1.14.1 Business Overview
12.1.14.2 Products Offered
12.1.15 Optrascan, Inc.
12.1.15.1 Business Overview
12.1.15.2 Products Offered
12.1.15.3 Recent Developments
12.1.16 Glencoe Software, Inc.
12.1.16.1 Business Overview
12.1.16.2 Products Offered
12.1.17 Aiforia Technologies Oy
12.1.17.1 Business Overview
12.1.17.2 Products Offered
12.1.17.3 Recent Developments
12.1.18 Paige
12.1.18.1 Business Overview
12.1.18.2 Products Offered
12.1.18.3 Recent Developments
12.1.19 Inspirata, Inc.
12.1.19.1 Business Overview
12.1.19.2 Products Offered
12.1.19.3 Recent Developments
12.1.20 Proscia, Inc.
12.1.20.1 Business Overview
12.1.20.2 Products Offered
12.1.20.3 Recent Developments
12.2 Other Players
12.2.1 Pathai
12.2.2 Konfoong Biotech International Co. Ltd.
12.2.3 Mikroscan Technologies, Inc.
12.2.4 Motic Digital Pathology
12.2.5 Kanteron Systems
13 Appendix
For more information about this report visit
Media Contact:
Research and Markets
Laura Wood, Senior Manager
[email protected]
For E.S.T Office Hours Call +1-917-300-0470
For U.S./CAN Toll Free Call +1-800-526-8630
For GMT Office Hours Call +353-1-416-8900
U.S. Fax: 646-607-1907
Fax (outside U.S.): +353-1-481-1716
Logo:
SOURCE Research and Markets
合作
100 项与 Mikroscan Technologies, Inc. 相关的药物交易
登录后查看更多信息
100 项与 Mikroscan Technologies, Inc. 相关的转化医学
登录后查看更多信息
组织架构
使用我们的机构树数据加速您的研究。
登录
或

管线布局
2026年02月08日管线快照
无数据报导
登录后保持更新
药物交易
使用我们的药物交易数据加速您的研究。
登录
或

转化医学
使用我们的转化医学数据加速您的研究。
登录
或

营收
使用 Synapse 探索超过 36 万个组织的财务状况。
登录
或

科研基金(NIH)
访问超过 200 万项资助和基金信息,以提升您的研究之旅。
登录
或

投资
深入了解从初创企业到成熟企业的最新公司投资动态。
登录
或

融资
发掘融资趋势以验证和推进您的投资机会。
登录
或

生物医药百科问答
全新生物医药AI Agent 覆盖科研全链路,让突破性发现快人一步
立即开始免费试用!
智慧芽新药情报库是智慧芽专为生命科学人士构建的基于AI的创新药情报平台,助您全方位提升您的研发与决策效率。
立即开始数据试用!
智慧芽新药库数据也通过智慧芽数据服务平台,以API或者数据包形式对外开放,助您更加充分利用智慧芽新药情报信息。
生物序列数据库
生物药研发创新
免费使用
化学结构数据库
小分子化药研发创新
免费使用